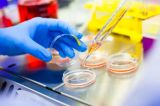
Japonia autorizează primele terapii cu celule stem reprogramate pentru Parkinson și insuficiență cardiacă

Realitatea Medicala - Știri de Ultimă Oră
În trend
Urmărește-ne pe
Sanatate publica
Descoperă
Actualitate
Cinci decese cauzate de gripă într-o săptămână. 83 de oameni au murit de la începutul sezonului
Actualitate
Bacteria asociată cu infecțiile respiratorii ar putea avea legătură cu boala Alzheimer, sugerează un studiu
Actualitate
România, 85% din cazurile de rujeolă din Europa. Ministrul Sănătății: „Dezinformarea este la cote alarmante”
Actualitate
Cauza principală care contribuie semnificativ la complicaţiile diabetului de tip 2, potrivit unui studiu internaţional
Actualitate
România extinde rețeaua pentru boli rare: 7 noi centre de expertiză, totalul ajunge la 58 la nivel național
Actualitate
Cele mai sățioase alimente. Țin de foame și sunt prietenoase cu silueta. Care este recomandarea Mihaelei Bilic?
Actualitate